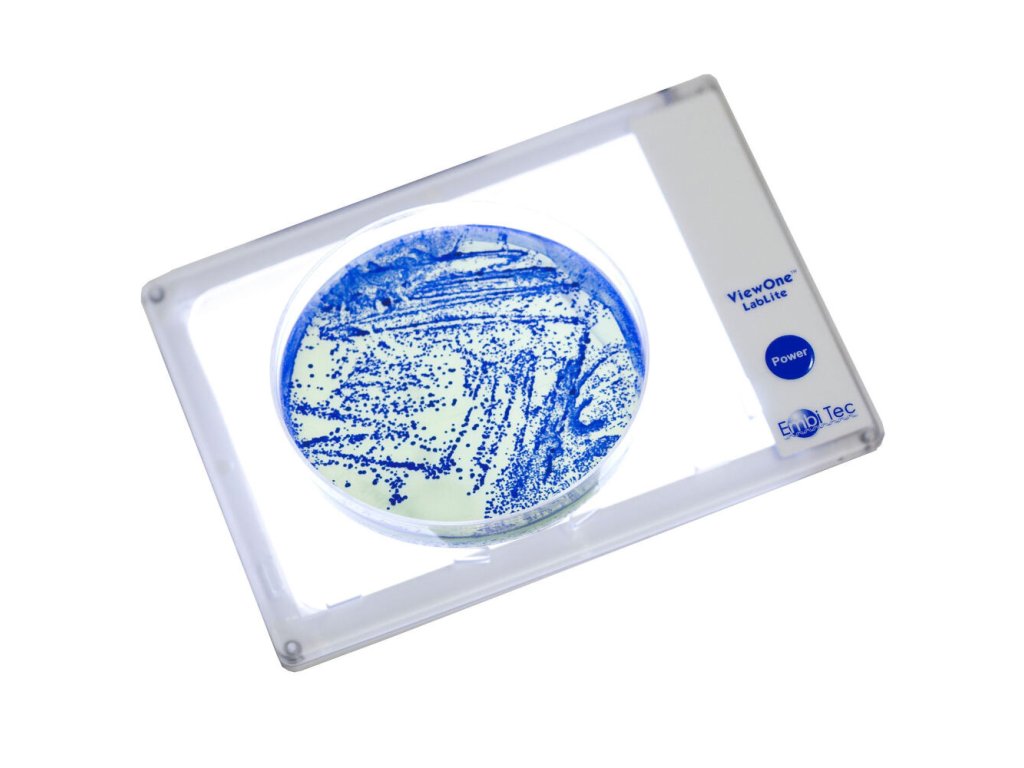
Transiluminátor ViewOne LabLite Embitec

Transiluminátor ViewOne LabLite | Embitec
Transiluminátor ViewOne LabLite je kompaktný biely LED svetelný box vhodný na osvetlenie vzoriek, Petriho mís alebo 96-well platničiek, s nastaviteľným jasom a nízkou výškou.
Transiluminátor ViewOne LabLite od Cleaver Scientific je praktické zariadenie určené na kvalitné zadné osvetlenie vzoriek v laboratóriu. Poskytuje rovnomerné biele LED osvetlenie, ktoré je možné regulovať v niekoľkých stupňoch jasu podľa potreby vzorky a prostredia.
Tento svetelný box má kompaktné rozmery a nízku výšku, vďaka čomu sa ľahko umiestňuje pod mikroskopy, naddosky alebo do obmedzených priestorov. Je ideálny na osvetlenie transparentných vzoriek, Petriho misiek, mikroplatničiek (96-well) či agárových dosiek.
Zariadenie ponúka plug & play pripojenie s štandardným napájaním (napr. 100–240 V), čo umožňuje jednoduché nasadenie v rôznych laboratórnych podmienkach. Vďaka nízkej hmotnosti a robustnému dizajnu je vhodné aj na mobilné či prenosné použitie pri vizualizácii vzoriek.
ViewOne LabLite je spoľahlivý a efektívny transiluminátor – vhodný pre laboratóriá, ktoré potrebujú univerzálne, kompaktné a kvalitné osvetlenie vzoriek bez potreby UV žiarenia.
Buďte prvý, kto napíše príspevok k tejto položke.
Cleaver Scientific, značka Thistle Scientific vyrábajúca v Spojenom kráľovstve, sa špecializuje na výrobu elektroforéznych systémov a príslušenstva, ako sú agarózové a PAGE gély, elektroblotters, napájacie zdroje a gel dokumentačné systémy. Ich produkty sú navrhnuté pre oddelenie DNA, RNA a proteínov, poskytujú spoľahlivú a cenovo dostupnú technológiu pre molekulárne laboratóriá na celom svete. Cleaver je známy vysokou kvalitou, technickou podporou, výrobou "Made in UK" a ISO 9001 certifikáciou.